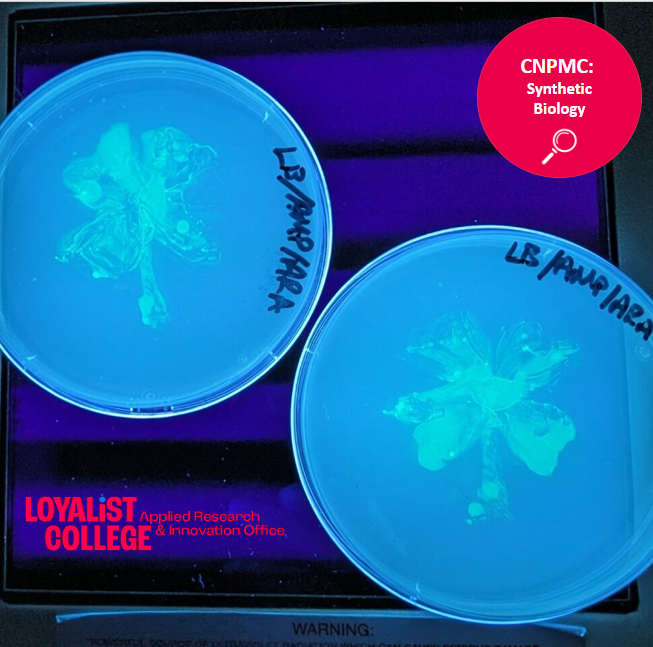
Our extractions aren’t the only thing that’s green! At the CNPMC, we're embarking on a journey of expansion into #syntheticbiology. Stay tuned for more news, where we'll showcase how CNPMC is leveraging #synbio to drive innovation across industries. #LoyalistResearch

Loyalist Research
@loyalistr
Loyalist College’s Applied Research & Innovation Office helps industries collaborate with academia in various applied research projects.
Visit our website ⬇️
ID: 1258769805815005184
http://www.loyalistappliedresearch.com 08-05-2020 14:44:55
590 Tweet
129 Takipçi
193 Takip Edilen





🔎 Get to know Loyalist College's Centre for Natural Products and Medical Cannabis (CNPMC)! Did you know that at the CNPMC, we offer a wide range of analytical testing services tailored to various industries? #appliedresearch #productdevelopment #innovation #naturalproducts





Join us for an exciting solar eclipse event at Loyalist College! This event will feature talks by two presenters from the Canadian Institute for Theoretical Astrophysics (Canadian Institute for Theoretical Astrophysics), before the eclipse reaches totality on April 8th. #Solareclipse #Belleville #UofT #BayofQuinte


Free event reminder! Join us ahead of the total eclipse on Monday, April 8, as the Applied Research and Innovation Office (ARIO) welcomes guest lecturers Milan Ilnyckyj and Anna Tsai from the Canadian Institute for Theoretical Astrophysics (Canadian Institute for Theoretical Astrophysics) at University of Toronto. ☀️



Are you a #producer or #smallfoodprocessor looking to value-add or #scaleup? Register for this workshop using the link below. Hosted by @OMAFRA at Loyalist College. You'll also have a chance to tour the Centre for Natural Products! surl.li/skytx #FoodResearch


Meet Clara I. Tascón, PhD., Senior Research Specialist for the Centre for Healthy Communities (CFHC). Dr. Tascón joined the Applied Research and Innovation Office (ARIO) at Loyalist College this month, and we are thrilled to welcome her to this new role! #AppliedResearch


Meet Amanda Solmes, Research Associate for the Centre for Healthy Communities (CFHC). Amanda joined the Applied Research and Innovation Office (ARIO) at Loyalist College this month, and we are excited to welcome her to this new role.


Meet Meghna, Loyalist College's Let's Talk Science student coordinator! She loves connecting with fellow students and helping them thrive academically. ARIO is proud to be the part of LTS, as it connects the world of STEM with education. #STEM #AppliedResearch